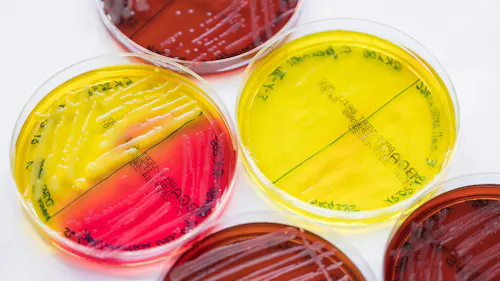
der kampf gegen die antibiotika-resistenz der kampf gegen die antibiotika-resistenz

market|5 mins Lesen
Der Kampf gegen die Antibiotika-Resistenz
1. April 2020
Zufriedenheit schien immer schwer zu greifen und vor allem schwer zu messen. Mithilfe des Net Promoter® Score (NPS) lässt sich ablesen, inwiefern Konsumenten ein Produkt oder eine Serviceleistung weiterempfehlen würden. Einen Einblick hierzu gibt Philipp Moder, Experte und Referent für die Themen B2B Vertrieb, Digitalisierung, Net Promoter® Score und Marketing Automation in unserem neusten Blogbeitrag und erläutert, wie wichtig Empathie ist, um neben Treue auch Loyalität zu schaffen.
Text von AXA Partners
Foto von Unsplash
Oktober 2021
Philipp Moder ist Experte und Referent für die Themen B2B Vertrieb, Digitalisierung, Net Promoter® Score und Marketing Automation. Weiter ist er KeynoteSpeaker, Autor und Blogger vieler Artikel und Studien rund um die Themen Kundenbindung, Inbound Marketing und Social Selling.
Der leidenschaftliche 1.FC Nürnberg-Fan ist Gründer und geschäftsführender Gesellschafter der Phocus Direct Communication GmbH in Nürnberg und einer der ersten zertifizierten NPS(r)-Experten in Deutschland. Als großer Befürworter der Unternehmensstrategie „Unternehmen 3.0“ absolvierte Philipp Moder 2012 seine Ausbildung zum Social Impact Entrepreneur. Als Social Impact Entrepreneur steht für ihn die Förderung der Entwicklung von Menschen, Teams und Organisationen, um sie zukunftsfähiger aufzustellen, im Fokus. Seit 2016 ist er einer der Experten zu dem Thema Digitalisierung von Marketing und Vertrieb von I4.0 EXPERTS.
Eine weitere Passion von Philipp Moder sind Befragungen zur Kundenzufriedenheit und Kundenloyalität auf Basis des Net Promoter® Score. Die von der Phocus Direct Communication konzipierten und umgesetzten Befragungen beinhalten seit 2004 bereits die Erhebung des NPS®. In 2013 absolvierte Philipp Moder die erste Ausbildung und Zertifizierung, die in Deutschland stattgefunden hat und ist somit einer der ersten NPS®-Experten mit dem offiziellen Titel des „Net Promoter Certified Associate“. Darüber hinaus war Philipp Moder der erste offiziell zertifizierte Inbound Sales Experte in Deutschland.
Wieso sind Kundenbindung und Kundentreue eigentlich zwei verschiedene
Angelegenheiten?
Der Unterschied zwischen Kundenbindung und Kundenloyalität lässt sich sehr plausibel erklären: Kundenbindung ist vereinfacht gesagt das, was künstlich vom Unternehmen ausgeht, wenn man versucht, den Kunden durch verschiedene Maßnahmen an sich zu binden. Kundenloyalität ist für mich genau andersherum: Kundenloyalität ist das, was der Kunde intrinsisch zum Unternehmen empfindet.
Wie würden Sie Kundenloyalität definieren?
Loyalität ist im Businesskontext oft schwierig zu definieren, aber man kann zur Erklärung ein anderes emotionales Thema wie zum Beispiel Fanliebe beim Fußball heranziehen – ich bin zum Beispiel Fan vom 1. FC Nürnberg und da wissen die Fußballfans gleich: das ist nicht leicht. Seit drei Jahren muss ich leiden, aber trotzdem stehe ich bedingungslos hinter dem Verein. Also ich bin einer der loyalsten Fans, die es gibt. Schlüsselt man das jetzt auf, sieht man schön diesen Unterschied von Bindungen zu Loyalität oder auch von Zufriedenheit zu Loyalität – manche Stimmen behaupten, dass Loyalität eine hohe Zufriedenheit erfordert. Das stimmt aber eben nur bedingt: Fans eines Vereins und auch einer Marke verzeihen tatsächlich auch mittelmäßige Leistungen – zumindest temporär. Es gibt durchaus auch Kunden, die übergangsweise oder phasenweise unzufrieden sind, aber trotzdem loyal bleiben. Setzt sich die schlechte Leistung oder Qualität natürlich kontinuierlich fort und würde aus dieser phasenweisen Unzufriedenheit eine konsistente Unzufriedenheit, dann ist natürlich auch die Loyalität irgendwann weg.
Als NPS-Experte, das für „Net Promoter Score“ steht, sehe ich primär die zwei Faktoren Weiterempfehlungsbereitschaft und Wiederkaufabsicht. Das sind die kommerziellen Dimensionen in der Thematik. Die Loyalität ist natürlich auch schon sehr stark, aber wirtschaftlich geht es immer um Kopf und Herz.
Können Sie den Net Promoter Score einmal erklären?
Es gibt ja unendlich viele verschiedenen Metriken, mit denen man Zufriedenheit oder Loyalität messen kann: den Customer Engagement Score oder auch den Customer Satisfaction Index und unzählige andere Messsysteme. Die meisten dieser Metriken zielen aber sehr stark auf den Aspekt Zufriedenheit ab. Wir haben aber gelernt, dass der große Unterschied zwischen Zufriedenheit und Loyalität primär darin begründet ist, dass Zufriedenheit immer eine retroperspektive Wahrnehmung ist. Ich kaufe etwas oder nehme eine Leistung in Anspruch, ich habe eine Erwartungshaltung, die dann entweder „erfüllt“, „nicht erfüllt“ oder „übererfüllt“ wird. Dann bin ich halt „zufrieden“, „nicht zufrieden“ oder „begeistert“. Aber das geht immer in die Vergangenheit – Loyalität ist damit nicht zu erfassen. Der Net Promoter Score ist hingegen nach vorne gerichtet, weil er zukünftiges Verhalten erfasst und misst. Es geht bei NPS um das Thema: ist der Kunde bereit, nochmal bei uns zu kaufen und würde er uns auch weiterempfehlen? Dabei wird in der NPS-Messung versucht, beide Dimensionen zu kombinieren – also die Zufriedenheit in der Vergangenheit und die Loyalität für die Zukunft.
„Zufriedenheit liegt in der Vergangenheit, Loyalität gilt für die Zukunft.“
Dabei ist NPS sehr einfach zu interpretieren: es gibt eine Skala bis zehn, die Messergebnisse werden in drei Gruppen aufgeteilt. Wer von neun bis zehn bewertet, gilt als „Promotor“, quasi einer der Marke. Die Gruppe rund um sieben und acht sind die, wo man sagen kann, das ist ganz ok – in der Methodik die Gruppe der „passiv Zufriedenen“. Ab sechs und weniger werden als die sogenannten „Kritiker“ bezeichnet. Bei diesen Kritikern gehen wir davon aus, dass die nicht wiederkommen und dass die auch nicht weiterempfehlen werden. Das Ergebnis des NPS errechnet dann den Prozentsatz der Promotoren und Kritiker, man zieht die Kritiker von den Promotoren ab und berücksichtigt die Passiven nicht. Das Ergebnis ist sehr klar auch als Management Summary nutzbar, man muss nicht Statistik studiert haben, damit man das Ergebnis versteht. Trotzdem kann man damit auch eine kaufmännische Korrelation sehen, über die man die Promotoren ansprechen kann, die einfach mehr Umsatz generieren werden, was das Geschäft auch profitabler macht. Das ist belegbar, das ist kein Voodoo.
Wie viel Einfluss auf den Wandel haben die nachrückenden, jungen Generationen mit ihrem veränderten Kommunikationsverhalten?
Zuerst einmal ist die Vielfalt der Optionen für Kunden durch das digitale Zeitalter signifikant gestiegen. Damit nimmt naturgemäß diese unbedingte Treue ab, weil einfach mehr Auswahl da ist, sprich: Konkurrenz lauert überall. Die Konsumenten haben sich auch grundsätzlich verändert: man kauft seine Milch bei Aldi und holt sich aber sein Abendessen bei Karstadt unten in der feinen Markthalle, ohne dass das irgendwie widersprüchlich erscheint. So verschwimmen die Verhaltensweisen – die einst klaren Kanten und deutlichen Abgrenzungen gibt es nicht mehr dank der Vielfalt der Optionen.
Hat die digitale Customer Experience einen Einfluss auf die Loyalität oder ist Leistung des Produktes stärker?
In der frühen Phase hat die Customer Experience definitiv einen hohen Einfluss auf die Kaufentscheidung, aber irgendwann ist der digitale Gap auch übersprungen und es geht um direkten, menschlichen Kontakt. Aber am Anfang ist es extrem hoch, weil der erste Touchpoint heute in der Regel ein digitaler ist. Auf der Webseite oder im sozialen Netzwerk oder wo auch immer halt dieser diese erste Touchpoint mit der Marke ist, wenn der nicht befriedigend ist, dann ist der Interessent schneller weg, als man gucken kann.
Was halten Sie für das Wichtigste in der Kundenbeziehung?
Empathie. Dazu möchte ich zwei schöne Beispiele vorstellen. Ein Softwareunternehmen musste als Reaktion auf die erhöhte Anzahl der Supportanfragen während der Pandemie an den Helpdesk einen Anrufbeantworter schalten, weil sie einfach nicht mehr jeden Anruf annehmen konnten. Sie haben aber jedem zurückgerufen. Sie haben natürlich ein branchenübliches Ticketsystem im Einsatz, was völlig ohne jeden direkten menschlichen Kontakt funktioniert – man schickt sein Support-Ticket, die IT arbeitet das ab und im Idealfall wird das Problem gelöst – irgendwann. Aber in einer Befragung kam ganz klar heraus, dass die Kunden sagten, dass sie sich über den Anrufbeantworter gefreut haben – also vielmehr natürlich über den persönlichen Rückruf.
„Ein Ticketsystem kann menschliche Empathie also niemals ersetzen.“
Die andere Geschichte, die ich über die Kraft der Empathie erzählen möchte, kommt von einem Healthcare-Unternehmen in den USA, das MRT-Geräte baut. Einer der Geschäftsführer hat ein Krankenhaus besucht, in dem ein MRT der Firma im Einsatz ist und war dann vormittags in der Radiologie. Dort hat er dann mitbekommen, dass fast 90% der Kinder vor der MRT–Untersuchung Beruhigungsmittel verabreicht bekommen mussten, weil die so viel Angst hatten. In einem MRT hämmert es; das ängstigt Kinder sehr. Der Firmenvertreter war völlig schockiert, dass Kinder regelrecht betäubt werden müssen, um diese medizinischen Untersuchungen über sich ergehen lassen zu können. Er hat dann darüber nachgedacht, was man tun kann. Die Lautstärke in dem Gerät ist systembedingt und lässt sich nicht ändern. Aber man kann die Umstände verändern – man hat also die Räume umgestaltet und die MRTs als einen integralen Bestandteil einer Kinderwelt gestaltet. Die Röhre war dann zum Beispiel wie die Kabine auf einem Schiff gebaut. Das Resultat: die Quote der Kinder, die man medikamentös ruhigstellen musste, ist von 90 % auf 2 % gefallen. Nur als Resultat der Empathie des Geschäftsführers, der sich in das Wesen der Kinder hineinversetzen konnte. Es geht im Geschäftsleben natürlich nicht nur um Menschlichkeit, aber das hat sich auch wirtschaftlich ausgezahlt: Die Radiologen müssen weniger Wiederholungen von den Aufnahmen machen und die Untersuchungen gingen viel schneller. Das ist ein geldwerter Vorteil. Und das aus der einfachen Erkenntnis heraus „Wir könnten das Produkt nicht ändern, aber wir können das Erleben verbessern“. Empathie pur im Grunde.
Was sind die größten Fehler, die ein Unternehmen begehen kann?
Nicht den Kunden fragen. Es ist erstaunlich, aber es ist keine Selbstverständlichkeit, regelmäßige Kundenbefragungen durchzuführen. Unternehmen werben mit ihren 100 oder 200 Jahren Erfahrung, dass sie Marktführer sind und die Kundenzufriedenheit sei ihr größtes Gut. Aber wenn wir dann die Verantwortlichen fragen, wie zufrieden ihre Kunden tatsächlich sind, treffen wir oft auf eine gewisse Ahnungslosigkeit. Dem Kunden wirklich eine Stimme zu geben und regelmäßig dieses Feedback, eine Sichtweise oder eine Wahrnehmung der Kunden einzufordern – das ist lange nicht selbstverständlich. Wir fangen immer damit an, die Kunden zu fragen, wie sie das Unternehmen sehen und was sie sich wünschen. Das ist letztlich auch wieder eine Frage der Empathie, die Wahrnehmung der Käufer wirklich verstehen zu wollen.
Und natürlich umgekehrt: was muss man unbedingt richtig machen?
Gut zuhören und das Feedback vor allen Dingen auch ernst nehmen. Denn das zu ignorieren, was man abgefragt hat, wäre wirklich sträflich dumm!
Net Promoter Score
Der Net Promoter Score (NPS) bzw. Promotorenüberhang ist eine Kennzahl, die misst, inwiefern Konsumenten ein Produkt oder eine Dienstleistung weiterempfehlen würden. In bestimmten Branchen korreliert der Net Promoter Score mit dem Unternehmenserfolg. Die Methode wurde von Satmetrix Systems, Inc., Bain & Company und Fred Reichheld entwickelt. Berechnet wird der Net Promoter Score durch die Differenz zwischen Promotoren und Detraktoren des betreffenden Unternehmens. Der Anteil der Promotoren und Detraktoren wird ermittelt, indem einer repräsentativen Gruppe von Kunden ausschließlich die Frage gestellt wird: „Wie wahrscheinlich ist es, dass Sie Unternehmen/Marke X einem Freund oder Kollegen weiterempfehlen werden?“ Gemessen werden die Antworten auf einer Skala von 0 (unwahrscheinlich) bis 10 (äußerst wahrscheinlich). Als Promotoren werden die Kunden bezeichnet, die mit 9 oder 10 antworten. Als Detraktoren werden hingegen diejenigen angesehen, die mit 0 bis 6 antworten. Kunden, die mit 7 oder antworten, gelten als „Indifferente“.
Kernelement der Systematik ist dabei, auf Basis des Kundenfeedbacks Veränderungsprozesse im Unternehmen in Gang zu setzen. Wird der NPS richtig angewendet und durch ein Customer Experience Management (CEM) System unterstützt, dann kann damit Folgendes erreicht werden:
Während der Umfrage können identifizierte Kritiker (Detraktoren) kontaktiert und die Ursachen für ihre schlechte Bewertung beseitigt werden. Promotoren werden als solche identifiziert. Sie sind dem Unternehmen wohlgesonnen und können für das Unternehmen hilfreich sein, wenn sie diese für Fallstudien zur Verfügung stehen oder in den Produktentwicklungsprozess einbezogen werden können etc. Konzeptionelle und strategische Verbesserungsmaßnahmen können abteilungs- bzw. bereichsbezogen identifiziert und umgesetzt werden. Sowohl das Middle Management als auch die obere Führungsebene können erkennen, welche Maßnahmen erforderlich sind, um die Organisation auf den Kunden zu zentrieren. (Quelle Wikipedia)